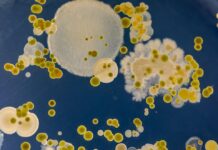
Парадокси в лечението с антибиотици и как губим битката срещу бактериите

Съхраняването на яйцата в хладилника наистина е по-добрe, отколкото на стайна температура, но има някои особености.
Как да удължим свежестта на продукта, споделя популярният готвач Мери Бери. Готварският гуру съветва да съхранявате яйцата в опаковка на рафта на хладилника, за да избегнете температурни промени.
Мери предлага да държите яйцата далеч от силно миришещи храни, тъй като те могат да абсорбират миризмата. Експертите също споделят този подход.
„Температурните различия могат да доведат до образуване на конденз върху черупките на яйцата, което може да насърчи растежа на бактериите. Не поставяйте яйца близо до задната част на хладилника, където температурата може да е по-ниска“, споделя Джена Кели, експерт по безопасност на храните.